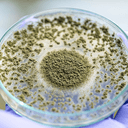
Proteases

Vitality
Nastartujte svůj organismus
Harmonelo VITALITY je jedinečným iniciátorem pro řadu důležitých procesů v našem těle, jako jsou podpora přirozené obranyschopnosti a trávení, normální stav pokožky, regenerace a detoxikace organismu. Obsahuje jedinečnou kombinaci aktivních enzymů papainu, bromelainu a proteáz. Aloe vera a vitamín C navíc působí jako účinné antioxidanty. VITALITY je tekutý doplněk stravy na bázi vlákniny z fruktooligosacharidlů, která jako prebiotikum účinně vyživuje naše přátelské střevní bakterie. Koupí tohoto produktu přispíváte do nadačního fondu HARMONELO HOPE.
Z každé prodané láhve věnujeme část výtěžku nadaci Harmonelo Hope.